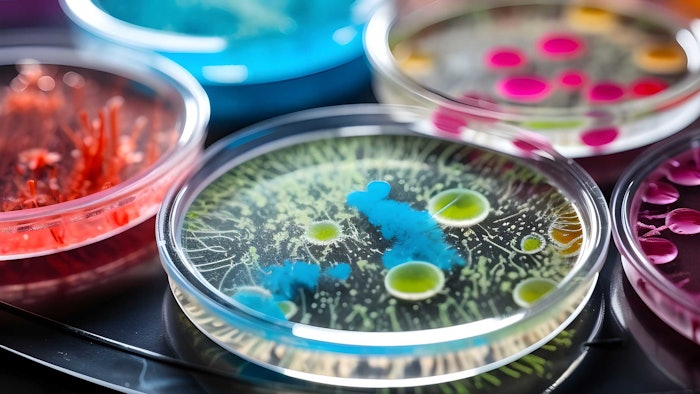
petri dishes microbe testing colorful spread out on surface

Image by Siarhei at Adobe Stock
Last week, we reported that for several years, especially with the advent of "alternative" preservatives, microbial contamination has been one of the most common reasons for cosmetic product recalls; although notably, the number of recent recalls in the U.S. has dropped dramatically.
Common Bacterial Contaminants
According to the source Microbe Investigations Switzerland, some of the most common and harmful bacteria that may contaminate cosmetics include:
- Staphylococcus aureus: Causing dermatitis, abscesses and systemic conditions like toxic shock syndrome;
- Pseudomonas aeruginosa: Commonly found in water-based preparations; causing infections, especially in those with weak immunity; and
- Escherichia coli : Causing gastrointestinal infections and other health issues.
Typical Yeast and Mold Contaminants
There are also yeast and molds to consider, typically:
- Candida albicans: A type of yeast, usually causing skin infection and other health issues;
- Aspergillus niger: A mold that usually causes respiratory problems and skin infections; and
- Penicillium species: Causing allergic reactions and cosmetic spoilage.
This made us wonder: how often do you test for microbial contamination during product development? Here's what you said. Be sure to check back for the next poll!
Poll Results
- At every stage 28%
- Only during final product testing 45%
- During specific development milestones 27%